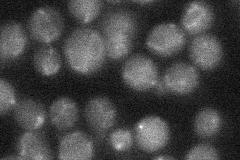
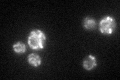

View description
Mitochondrial aminopeptidase; cleaves the N termini of at least 38 imported proteins after cleavage by the mitochondrial processing peptidase (MPP), thereby increasing their stability; member of the aminopeptidase P family
Localization:
Intensity:
Fold change:
Significance:
-
C’ GFP library in SD

mitochondria26.58 -
N' NOP1pr-GFP in SD

mitochondria132.557 -
N' TEF2pr-mCherry in SD

mitochondria20.7634 -
N' NATIVEpr-GFP in SD
mitochondria21.048 -
N' TEF2pr-VC and Cyto-VN in SD

#N/A0 -
C’ GFP library in SD+DTT
mitochondria33.421.25No -
C’ GFP library in SD+H2O2

mitochondria21.850.82No -
C’ GFP library in Starvation Media

mitochondria20.180.75Yes -
C’ GFP library on the background of Pup2-DaMP

mitochondria -
C’ GFP library on the background of CCT mutant

mitochondria32.63761.22746No
